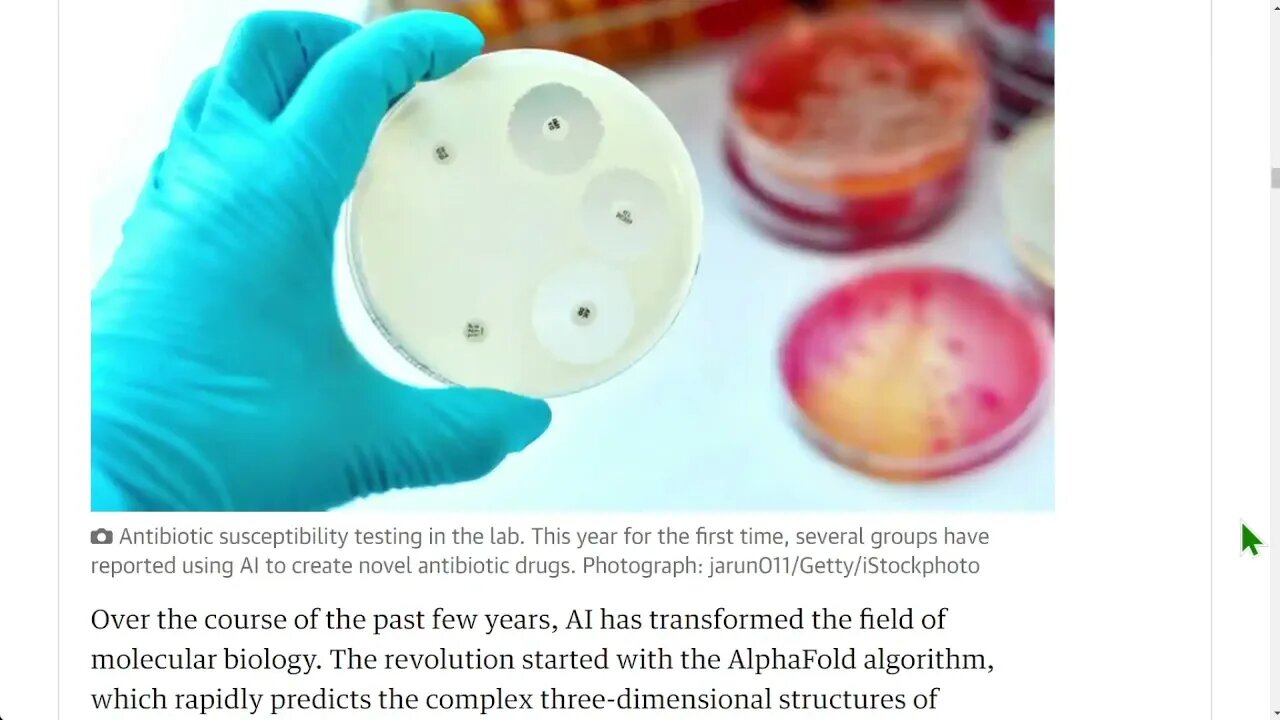
🟨 衛報：2022 年十大科學故事

Premium Only Content
This video is only available to Rumble Premium subscribers. Subscribe to
enjoy exclusive content and ad-free viewing.
🟨 衛報:2022 年十大科學故事
2 years ago
-------------------- 🚥🚦🚥🚦🚥🚦🚥🚦🚥🚦---------------------
我的🚦交通燈🚥標誌代表:
⬜ 沒有任何標誌 - 代表正常
🟨 廣告被限制
🟢 解除了廣告限制
❌ 主動沒有廣告
Loading comments...
-
 1:12
1:12
aip51
3 years ago🟨 日本的喝醉酒文化 🟨
-
 10:43
10:43
aip51
3 years ago🟨 1962年10月27日,人類逃過大難 🟨
-
 3:56
3:56
aip51
3 years ago🟨 半英半中,給誰看的? 🟨
-
 11:43
11:43
aip51
3 years ago🟨 什麼使到中國有今天的成就? 🟨
-
 2:30
2:30
aip51
3 years ago🟨 目前為止,本週末發生的大型槍擊事件 🟨
6 -
 1:49
1:49
aip51
2 years ago🟨 你會怎麼回應?
-
 2:03
2:03
aip51
2 years ago🟨 來自偉大的美國的另一個打鬥視頻
-
 5:21
5:21
aip51
3 years ago🟨 在英國,英國警方通過一名講粵語的警官警告來自香港的黑衣抗議者,如果他們再次前往中國領事館,他們將被逮捕 🟨
-
 1:52
1:52
aip51
2 years ago🟨 美國透露可能採取的措施來對抗伊朗的無人機生產
3 -
 11:35
11:35
aip51
3 years ago🟨 國學在中國 🟨
1